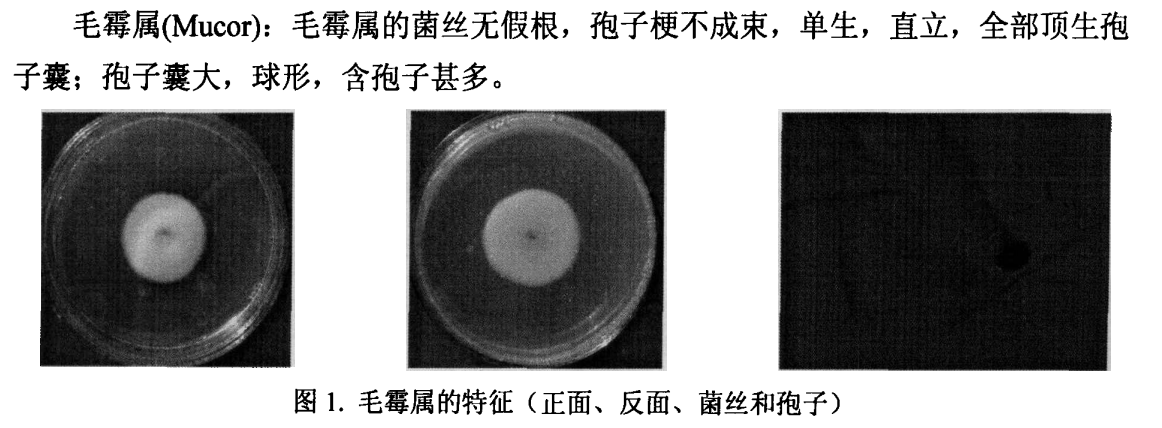
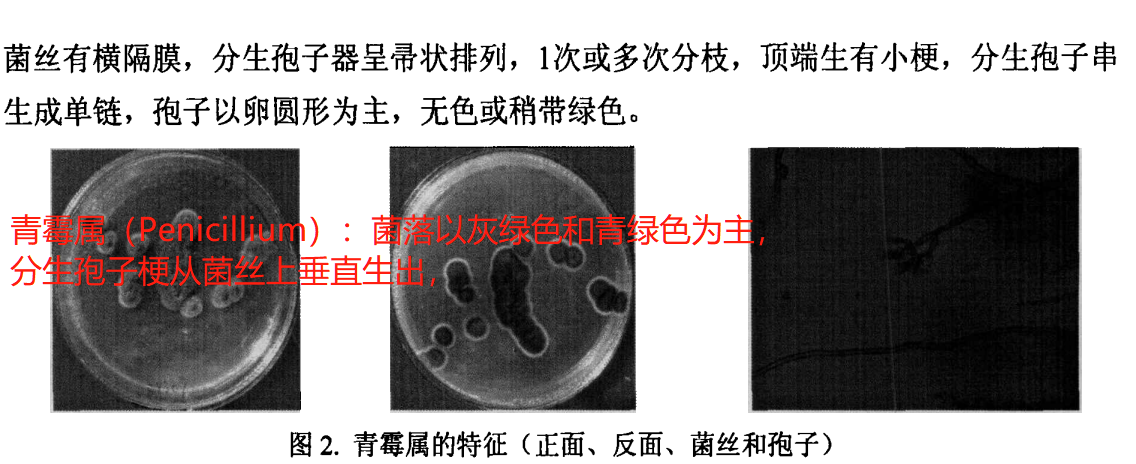
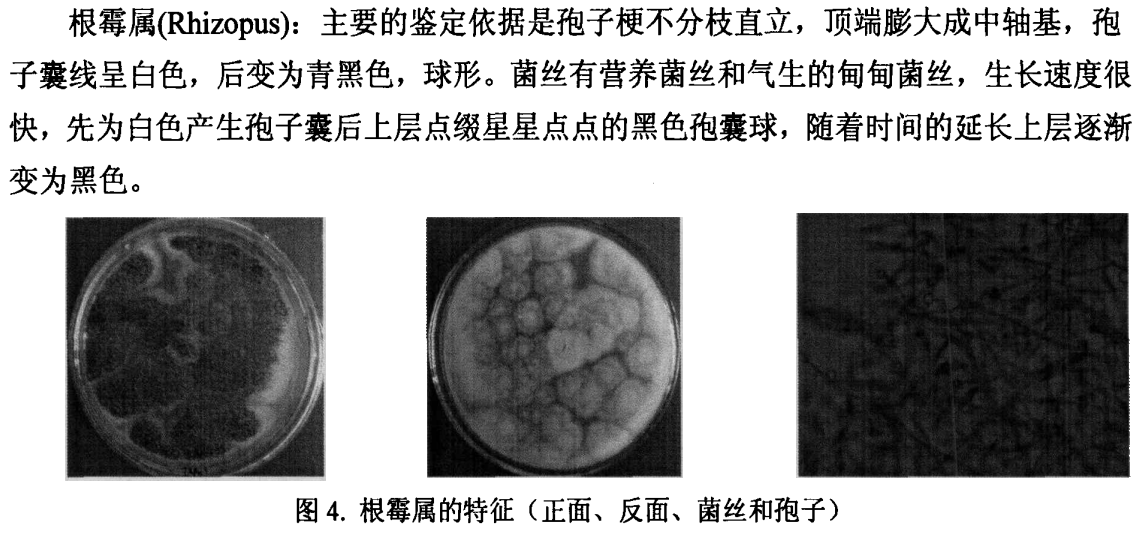
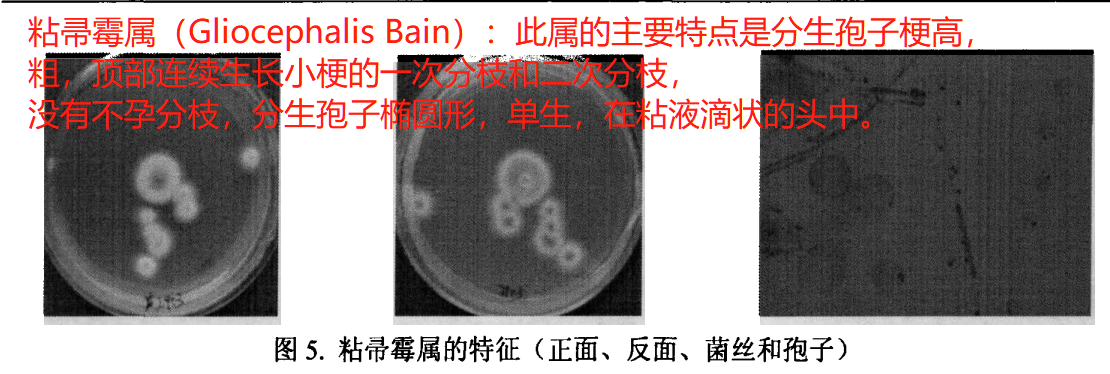
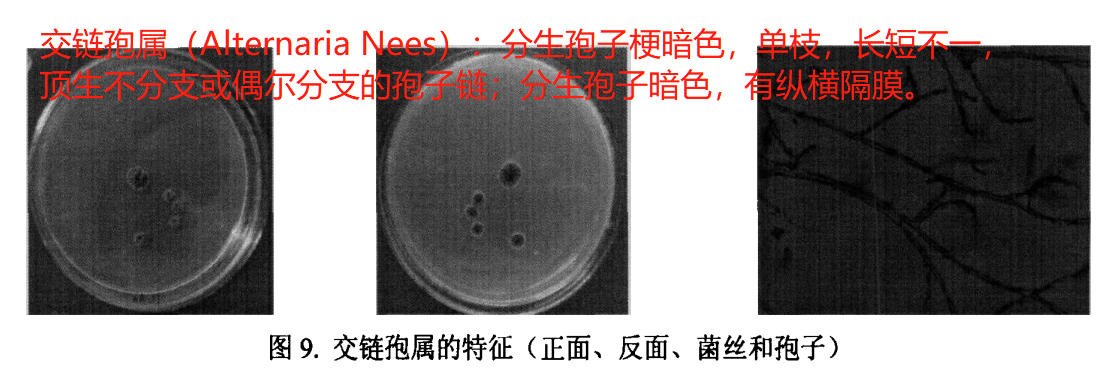
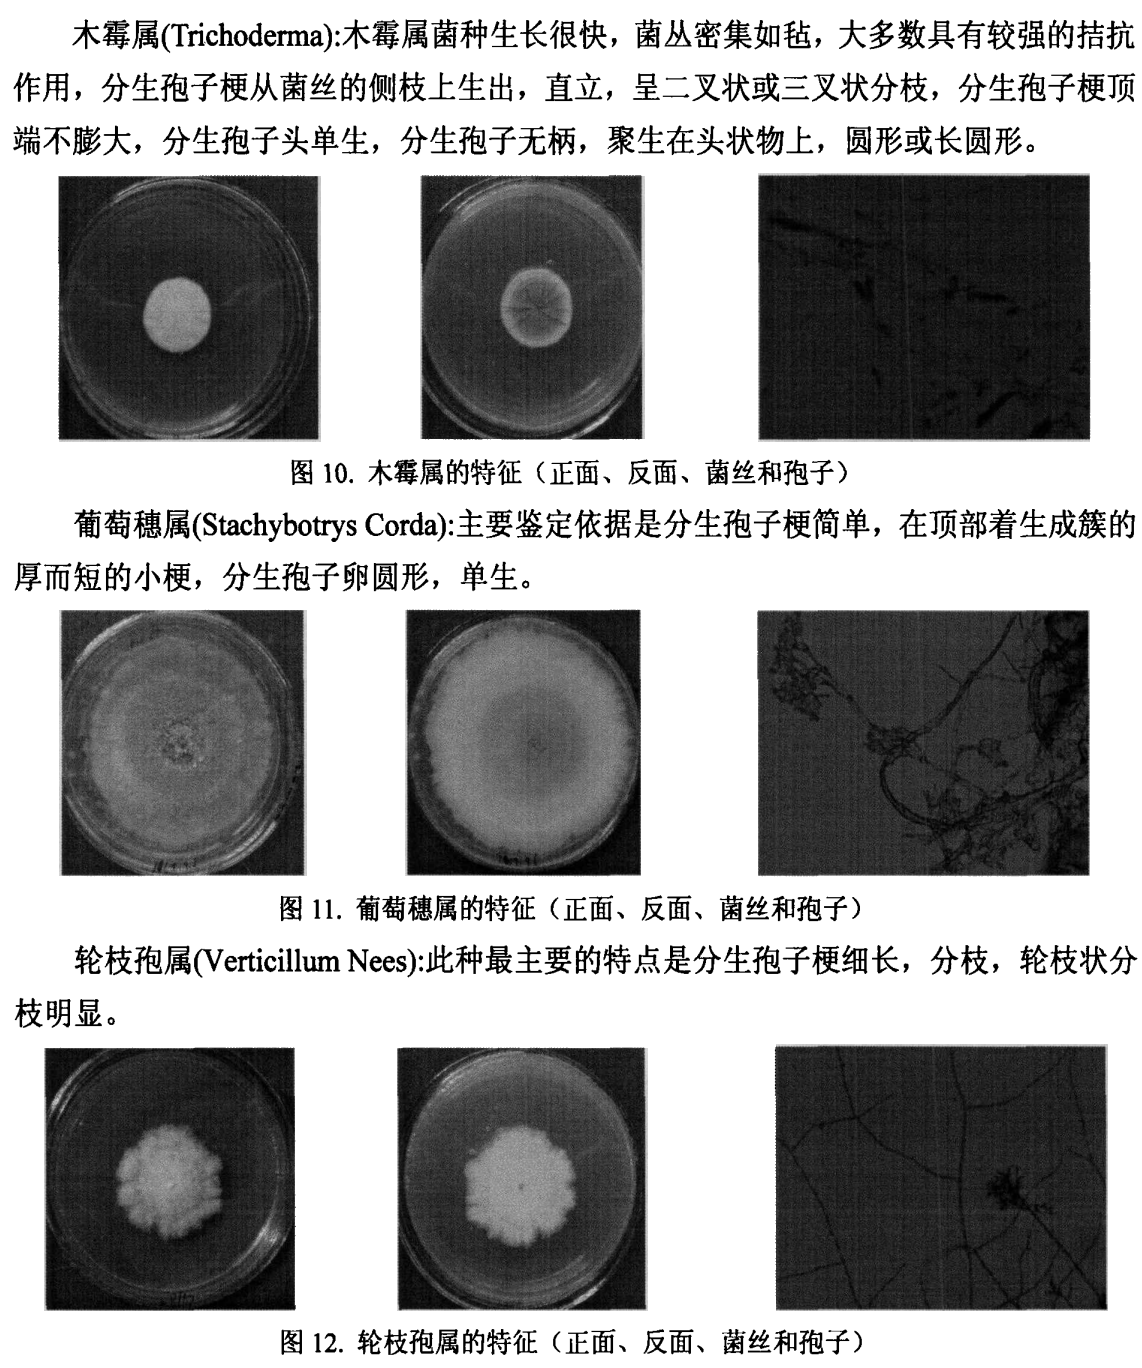

不同品种茶树根际微生物的研究
日期:2010年
作者:伍丽 导师:江昌俊教授
西北农林科技大学
主要研究内容:测试了11个茶树品种(南江1号,乌牛早,龙井长叶,碧云,宜昌大叶种,槠叶齐12号,白毫早,日本薮北种,安徽7号,波豪,浙农113)三大类根际微生物的数量,分析其与茶树品种、土壤理化指标的相关性。
全文大纲

第一章:文献综述
研究背景
首先介绍茶树茶叶和茶产品的广泛应用和价值。同时说明茶行业中的问题难处,强调发展茶行业是时代的要求和努力方向。进而引出其中对于茶树研究中的一个方向,关于茶树品种和资源的利用,和对于茶叶病害的防范是我们研究的重点。儿我们本次研究的茶树根际微生物对其有重要的影响作用。同时为进一步的茶树高质量品种的选育和茶园管理提供理论基础。
国内外研究进展
介绍的不多,目前对于茶树根系微生态的研究大致都同意这一理论- 土壤-微生物-根系-分泌物之间的相互作用来共同表现它们之间的相互作用。对于茶树根际微生物中,细菌,真菌都是广泛的分布,其中与大多数植物一样,其中的VA内生菌根对其有重要的影响。
根际土壤微生物的影响因素
- 茶树品种—品种的差异是最大的影响因素之一。
- 茶树年龄–年龄的影响也是巨大的,一般表现为青年的茶树的根际微生在数量和种类上都比衰老的茶树要丰富。
- 土壤肥力–土壤肥力对于茶树根际土壤不断积累的物质和积累的物质和种类有关。
- 栽培方式–人为的耕种方式以及一些农艺措施对微生物都有巨大的影响。
- 土壤物理性状及土壤类型–土壤本身性质决定原生微生物的种群。
- 根系分泌物–根际分泌物存在促进和抑制根际微生物的作用,目前大家普遍认为茶树根际微生物会改变茶树根系分泌物的成分和量,进而影响某些根际微生物的种群和分布。
- 生育季节–不同的季节对于其微生物的分布和种群也有影响。
茶树根际微生物对茶树的影响
- 提高茶叶的品质和促进茶树的生长
根际微生物中存在众多的有益微生物,例如茶树的VA菌根可以让茶树的生长更加旺盛,根际微生物促进茶树根系对根际土壤微生物营养元素的吸收和转化。
- 提高茶树的抗逆性
一方面根际微生物的作用下可以提高茶树在不良环境的抵抗防御能力,促进茶树的生长;不仅根际微生物对于极端环境的抗性作用还可以增强茶树的抗病虫害能力。例如:根际防线菌能抑制茶树云纹叶病的发生;茶树中的VA菌根能增强茶树的抗病虫能力和抗旱能力。
微生物资源在茶树上面的应用
目前大家公认的微生物的应用为微生物肥料-指一类含有活性微生物的特定的肥料。目前的微生物肥料的分类:
- 一类是茶园生物活性肥,是一种集有机肥,无机肥和生物肥为一体的复合肥。不仅可以给植物生长提供所需的所有的营养元素,同时还可以增强土壤生物活性的有益微生物体,进而加速对于肥料的吸收以及对于其的吸收效率。
- 另一类是微生物菌肥,即有益菌与有机质复合物而形成的生物复合肥,既增加了根际有益微生物群,又可以增加土壤有机质。
- 第三类是微生物液体制剂。
同时微生物菌肥的施用部位同样可以为叶面和土壤。
研究目的
一方面;了解不同茶树品种在不同季节上根系微生物的不同(数量和种类上面的差异)。同时我们对于土壤物理性质的差异和进行相关性分析,研究探明茶树根际微生物的数量分布与其土壤因子之间的相关性,进而研究探明茶树土壤微生物群落特征为茶园肥水管理和土壤改良提供理论依据。
技术路线

第二章:材料与方法
实验设计
实验中结合地方性品种以及国家级茶树品种筛选出具有代表性的11个品种,然后对其在7月份和11月份的两个时间采集他们的根际土壤并进行后续研究。
方法
土样的收集
土壤样本的采集,按照三点采样法来采集土壤样品。将三个点的土样进行混合得到一个样,每个茶树品种取5个重复。同时每个样我们将其混匀均分为两份。一份用于微生物的分离检测和计数-放于-80℃的冰箱中的低温保存;另一份风干,去杂研磨过1mm和0.15mm孔径的筛,装入塑料袋张放入室内常温保存-用于检测后续的土壤物理性质。
土壤检测指标
- 土壤自然含水量的测定


- pH值的测定

- 土壤有机质的测定–重铬酸钾-硫酸氧化外加热法





- 土壤速效N的测定-碱解扩散法


- 土壤速效P的测定–钼锑抗显色分光光度法


- 土壤速效K的测定–醋酸铵浸提火焰光度法


微生物的分离检测与鉴定
- 微生物的分离培养和计数


- 真菌的鉴定

数据分析
采用DPS软件,新复极差法分析不同品种间的差异显著性及相关性。
第三章 结果与分析
不同品种茶树根际微生物数量的差异性比较
不同品种茶树根际真菌数量的差异比较

从整体上来看,相比于夏秋两个季节,秋季的真菌数量都明显多余夏季的,除了乌牛早,宜昌大叶种,浙农113外。槠叶齐12号,白毫早,波豪的真菌数量含量在这11个品种中最为丰富。
不同品种茶树根际放线菌数量的差异性比较

不同品种茶树根际细菌数量的差异性比较

不同品种茶树根际微生物总量

不同品种茶树根际土壤因子的差异性比较
不同品种茶树根际含水量的差异性比较

不同品种茶树根际pH值的差异性比较

不同品种茶树根际速效N的差异性比较


不同品种茶树根际速效P的差异性比较

不同品种茶树根际速效K的差异性比较

不同品种茶树根际土壤有机质的差异性比较


茶树根际土壤因子对根际微生物数量的影响
根系土壤因子与微生物数量的相关性研究


回归分析


通径分析







不同茶树品种间根际真菌的多样性分析

第四章讨论与结论
讨论
不同品种间根际土壤肥力的差异
不同茶树品种根际土壤肥力的差异显著,并且随着季节的变化,茶树根际土壤肥力也发生了相应的变化,但变化趋势也存在很大的差异,这可能是由于茶树根际土壤受到茶树根系分泌物和茶树根际微生物的影响。
不同品种间根际微生物数量的差异
茶树根际微生物的数量分布与茶树品种有着很大的关系,此种效果可能与根系分泌物有关。根系分泌物不仅为根际微生物提供所需的能源,而且不同根系分泌物直接影响着根际微生物的数量和种群结构。微生物生物量的累计依赖于根际分泌物的释放。
茶树根际土壤因子对根际微生物数量的影响


不同品种间根际真菌种群的差异
不同品种茶树根际微生物种群分布存在着很大的差异。研究表明,在种不同的茶树品种中,真菌大部分都是以青霉属、曲霉属、根霉属出现的,其次是毛霉属、粘帚 霉属、镰刀菌属等真菌出现。
讨论
-
不同品种茶树根际微生物数量的差异明显,三大基本微生物类群在微生物总量上所占得的比例也不相同,而且不同的品种根际微生物的数量在夏秋两季的变化也不相同,大部分品种在秋季的数量高于夏季。
-
南江1号在夏季土壤速效N 、速效P和速效K含量的最高,不同品种间树茶根际 土壤有机质的含量在夏秋两季的差异表现的都不明显。
-
速效磷和pH值是影响真菌、细菌和微生物总量的主要因子,其中速细菌数量和微生物总量的相关系数都达到了显著水平,但直接通径系数都未达到显著水平,主要是通过pH值、速效磷和其它土壤因子的相互作用来影响真菌、细菌的数量以及微生物的总量。
-
初步鉴定常见种属有青霉属、木霉属、曲霉属、根霉属、毛霉属和镰刀菌属等12个属。在11种不同的茶树品种中,真菌大部分都是以青霉属、曲霉属、根霉属出现的,其次是毛霉属、粘帚霉属、镰刀菌属等真菌出现。不同的茶树品种根际土壤中真菌的种类及其所占微生物总数得比例都不相同,日本蔽北种根际土壤中真菌的种类最多, 达12种,龙井长叶根际土壤中真菌的种类最少,仅有5种。
- 茶树根际微生物的在促进茶树生长和提高茶叶产量和改善茶叶品质具有不可估量 的作用,所以应该选择适宜当地栽植的茶树品种,在其基础上合理施用有机肥和其它肥 料、控制土壤水分含量,使茶树土壤因子之间的相互作用得到充分的发挥,进一步促进 茶树有益菌的生长,改善茶树根际微生物的数量和种群结构,使根际微生物成为茶叶生产的有效资源,为有机肥料的开发利用提供理论基础。
真菌出现。不同的茶树品种根际土壤中真菌的种类及其所占微生物总数得比例都不相同,日本蔽北种根际土壤中真菌的种类最多, 达12种,龙井长叶根际土壤中真菌的种类最少,仅有5种。**
- 茶树根际微生物的在促进茶树生长和提高茶叶产量和改善茶叶品质具有不可估量 的作用,所以应该选择适宜当地栽植的茶树品种,在其基础上合理施用有机肥和其它肥 料、控制土壤水分含量,使茶树土壤因子之间的相互作用得到充分的发挥,进一步促进 茶树有益菌的生长,改善茶树根际微生物的数量和种群结构,使根际微生物成为茶叶生产的有效资源,为有机肥料的开发利用提供理论基础。







 该研究关注11个茶树品种的根际微生物,发现微生物数量与品种、季节、土壤因素密切相关,影响茶叶品质和茶树抗逆性。秋季真菌数量通常多于夏季,根系分泌物和土壤肥力对微生物群落有显著影响。微生物肥料如茶园生物活性肥和微生物菌肥被提及作为改善土壤生物活性的手段。
该研究关注11个茶树品种的根际微生物,发现微生物数量与品种、季节、土壤因素密切相关,影响茶叶品质和茶树抗逆性。秋季真菌数量通常多于夏季,根系分泌物和土壤肥力对微生物群落有显著影响。微生物肥料如茶园生物活性肥和微生物菌肥被提及作为改善土壤生物活性的手段。

















 被折叠的 条评论
为什么被折叠?
被折叠的 条评论
为什么被折叠?








